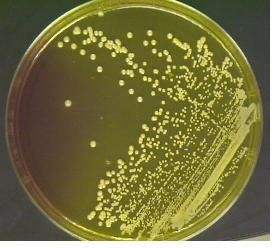
\

SCI论文(www.lunwensci.com):
摘要:目的探究新狼毒素B对由金黄色葡萄球菌引起的小鼠皮肤化脓性感染的治疗作用,观察其能否有效治疗局部皮肤化脓性感染,为临床治疗提供科学依据。方法选取40只清洁级6~7周龄昆明小鼠,适应性饲养1周后,建立40只由金黄色葡萄球菌引起的小鼠局部皮肤化脓感染模型,然后随机分为新狼毒素B组、红霉素组、鱼石脂膏组及对照组,将上述药物外敷于小鼠皮肤局部化脓处,连续给药1周、1次/d,可根据局部感染范围决定外敷用量,观察一周内化脓部位的皮肤变化。结果新狼毒素B对小鼠皮肤化脓性感染的治疗效果明显优于鱼石脂膏组(P<0.01)及对照(P<0.01),与红霉素组比较差异不明显(P>0.05)。结论新狼毒素B对皮肤化脓性感染具有明显治疗效果。
关键词:新狼毒素B;金黄色葡萄球菌;化脓性感染
本文引用格式:张书琳,范旭童,何爱玲,等.新狼毒素B对化脓性感染治疗作用的研究[J].世界最新医学信息文摘,2019,19(80):21-22.
Therapeutic Effect of Neochamaejasmine B on Suppurative infection
ZHANG Shu-lin1,FAN Xu-tong1,He Ai-ling2,LIU Wen-wen1,LI Ming1*
(1.Shandong First Medical University,Tai'an Shandong;2.Laboratory of Taishan sanatorium,Tai'an Shandong)
ABSTRACT:Objective To explore the therapeutic effect of Neochamaejasmine B on skin suppurative infection in mice caused by Staphylococcus aureus,and to observe whether it can effectively treat local skin suppurative infection,so as to provide scientific basis for clinical treatment.Methods Forty Kunming mice aged 6-7 weeks were selected and fed adaptively for one week.Forty mice with local skin purulent infection caused by Staphylococcus aureus were established.Then they were randomLy divided into Neochamaejasmine B group,erythromycin group,ichthyol group and control group.The amount of external application was determined and the skin changes at the suppurative sites were observed within a week.Results The therapeutic effect of Neochamaejasmine B was better than erythromycin group(P<0.05),ichthyol group(P<0.05)and control group(P<0.01).Conclusion Neochamaejasmine B has obvious therapeutic effect on skin suppurative infection.
KEY WORDS:Neochamaejasmine B;Staphylococcus aureus;Suppurative infection
0引言
金黄色葡萄球菌(Staphylococcus aureus)是社区及医院皮肤化脓性感染的主要致病菌,皮肤局部化脓性感染是指局部皮肤、皮下组织及肌肉筋膜的化脓性感染,其传播途径主要为细菌侵入破损皮肤、黏膜后引起的皮肤软组织感染。金黄色葡萄球菌是需氧或兼性厌氧型革兰阳性球菌的一种,广泛分布在自然界和医院环境中,金黄色葡萄球菌能够产生足够数量的凝固酶和外毒素,致病性强。由金黄色葡萄球菌所引起的局部皮肤软组织化脓性感染一般比较严重,主要有疖、痈、脓疙疮、毛囊炎、伤口感染、褥疮感染等,有的患者可出现葡萄球菌菌血症并伴有局部损害。
近年来,随着广谱抗生素和免疫抑制剂的广泛应用,金黄色葡萄球菌的耐药性日益严重,特别是耐甲氧西林金黄色葡萄球菌(MRSA)引起的化脓性感染的发病率越来越高,导致治疗困难。利用中药成分治疗金黄色葡萄球菌感染逐渐在临床上开始应用,瑞香狼毒作为一种中医普遍入药抑菌的中草药而受到了关注。新狼毒素B(Neochajasmine B)是一种存在于瑞香狼毒根中的天然双黄酮化合物,具有抗菌谱广、抗菌能力强和抗菌靶点新颖的特点,研究报道该化合物对多种植物病原菌和动物病原菌均具有良好的抑菌活性[1-2]。因其提取自中草药,故药效温和且不易产生耐药性,是一种理想的天然广谱抗菌物质。有研究表明,新狼毒素B在体外实验中具有良好的抑制金黄色葡萄球菌生长的作用,但目前体内实验尚未进行。本项目通过建立小鼠金黄色葡萄球菌皮肤化脓性感染模型,观察新狼毒素B局部外敷给药后的治疗效果,以期进一步探讨新狼毒素B对金黄色葡萄球菌的抗感染作用。
1材料与方法
1.1实验材料
1.1.1实验动物
健康昆明小鼠40只,6~7周龄,体重20~25g,小鼠为SPF级,由本院实验动物中心提供。饲养于独立通风换气笼中,置于标准实验条件(温度:20~25℃,湿度:50%~70%)中。动物实验研究遵循国家制定的有关实验动物保护和使用的指南,并经山东第一医科大学实验动物伦理委员会批准。
1.1.2试验菌株
金黄色葡萄球菌USA300为山东第一医科大学微生物免疫实验室保存。
1.1.3药物
新狼毒素B购自武汉天植生物技术有限公司,红霉素软膏购自辰欣佛都药业(汶上)有限公司生产,鱼石脂膏购自合肥亿城实验仪器有限公司。
1.1.4主要试剂
0.9%生理盐水购自泰安普天科技有限公司,75%酒精购自新乡市新兴生物科技有限公司,戊巴比妥钠南京皇泰医药科技有限公司,静脉留置针贴膜(3MTegadermFilmREF:1624W,USA);无菌纱布;无菌胶布;皮肤打孔器(直径15mm打孔器)均购自河南磊创医疗器械商贸有限公司。
1.2试验方法
1.2.1小鼠化脓性感染模型的建立
实验开始前对小鼠进行称重记录,1%的戊巴比妥钠(10mg/kg小鼠体重)腹腔注射行麻醉处理。用小动物剃毛刀于麻醉后小鼠背部备皮处理,并用生理盐水洗净擦干小鼠背部皮肤,以便后续伤口处贴膜固定。在完成脱毛处理后将小鼠背部朝上妥善固定于小动物试验台上,用75%酒精对小鼠背部进行消毒处理,准备手术。将打孔器与皮肤接触头进行消毒,后在小鼠背部行皮肤打孔处理,过程中保证无菌,打孔深度达到破坏肌肉层为止。用无菌纱布或者棉签擦拭伤口部位,以达到对伤口止血和清除伤口处血液。向小鼠伤口处滴加108 CFU/mL金黄色葡萄球菌菌液100L。用留置针贴膜妥善封闭伤口处,确保贴膜能够与皮肤紧密贴附,贴膜周围用临床无菌胶布再次固定,确保细菌能够足够时间的与伤口处组织接触[3-4]。待小鼠麻醉苏醒后将每只小鼠单独置于独立通气饲养笼(IVC)中饲养,饲养过程中对小鼠的生存状态、伤口感染变化情况等进行观察拍照记录,直至伤口处明显感染灶形成。
1.2.2试验分组
把制备的皮肤化脓性感染小鼠模型常规饲养,48h伤口处出现明显化脓灶显示造模成功。将40只小鼠局部化脓感染模型随机分为4组,每组10只,分别为新狼毒素B组、红霉素组、鱼石脂膏组及不用任何药物的对照组。
1.2.3给药方法
因新狼毒素B的水溶性差,为使其能很好的分散在外敷敷料中,选用DMSO做助溶剂。将新狼毒素B、红霉素与鱼石脂膏外敷于小鼠背部局部化脓感染处,根据局部感染范围决定外敷药量,连续给药1周、1次/d。为防止小鼠舔舐,用药后用透气敷料保护伤口。
1.2.4观察指标及评价标准
造模后观察感染灶情况及小鼠精神状况、进食情况、反应速度等。疗效判定标准:1周内脓栓脱落,脓液排出,伤口结痂,红肿等炎症完全消退为显效;1周内红肿范围缩小,仍有小脓栓,伤口未完全干燥,炎症未全消退为有效;1周内病灶无明显变化为无效。
1.2.5统计学处理
计量资料采用均数±标准差(±s)表示;使用SPSS 17.0统计学软件包进行统计学分析;计数资料采用卡方检验,计量资料比较采用方差分析(P<0.05)为差异有统计学意义。
2结果
2.1皮肤化脓性感染模型的建立
于小鼠伤口处滴加108 CFU/mL金黄色葡萄球菌悬液100L,造模成功率可达100%。建模24h后,小鼠精神状态明显变差,反应较慢,进食和饮水减少。伤口在24h左右初步形成淡黄色脓胎,48h能够看到明显的黄色脓胎形成,且感染伤口处较湿润,部分小鼠伤口有黄色脓液流出。
2.2新狼毒素B的治疗效果
新狼毒素B组显效9只(90%),有效1只(10%),总有效率100%;红霉素组显效6只(60%),有效3只(30%),总有效率90%;鱼石脂膏组显效3只(30%),有效4只(40%),总有效率70%;对照组显效0只(0%),有效2只(20%),总有效率20%,见表1。
3讨论
皮肤局部化脓性感染是指局部皮肤、皮下组织及肌肉筋膜的化脓性感染,感染的起因常是机体自身防御能力遭破坏,病原菌由破损的皮肤、黏膜侵入所致,感染处皮肤红肿、皮温增高、压痛、硬结、硬块或向心性蔓延的红痛条状物,脓肿形成时局部有波动感,甚至出现坏死、溃疡及功能障碍[5]。金黄色葡萄球菌是引起局部化脓性感染最常见的细菌,金黄色葡萄球菌引起的感染也一直是我国医院感染和社区感染的主要病原菌[6]。
近年来,由于各种抗菌药物的不合理使用,MRSA的检出率逐年增加并呈现多重耐药的趋势,给临床治疗带来了极大的困难。利用中药成分治疗该菌感染可视为解决这一问题的有效方法。瑞香狼毒,多年生草本植物,瑞香科,狼毒属,生长于温带地区[7]。瑞香狼毒化学成分复杂,目前研究的主要是该植物的黄酮类、木脂素、香豆素、二萜等成分。瑞香狼毒具有多种药理活性,如抗肿瘤活性、抗病毒活性、抗惊厥、抗癫痫活性以及抗菌活性等[8-9]。可能与其散结逐瘀之功效有关,中医普遍以狼毒入药抑菌。新狼毒素B是一种存在于瑞香狼毒根中的天然双黄酮化合物,有试验结果表明该化合物对多种植物病原菌和动物病原菌具有良好的抑菌活性,其抗菌谱广、抗菌能力强和抗菌靶点新颖,是一种理想的天然广谱抗菌物质。
本实验应用新狼毒素B治疗小鼠局部皮肤化脓感染取得了明显效果。我们采用皮肤局部化脓性感染最常见的致病菌金黄色葡萄球菌作为致病菌,建立小鼠皮肤局部化脓性感染模型,将新狼毒素B外敷用药,证实新狼毒素B对皮肤化脓性感染具有良好的治疗效果。结果表明新狼毒素B治疗效果明显优于鱼石脂膏组(P<0.01)及对照组(P<0.01),与红霉素组比较差异不明显(P>0.05)说明新狼毒素B能有效地控制皮肤化脓性感染,可作为治疗皮肤化脓性感染的有效药物之一,临床可以试用[10]。
参考文献
[1]李福华.新狼毒素B的抑菌活性构效关系研究IV[D].陕西:西北农林科技大学,2009.
[2]李晓惠,项勋,唐晓萍,等.瑞香狼毒研究进展[J].动物医学进展,2019,40(4):96-99.
[3]王永芳,李新宇,宋莎莎,等.单纯性浅表皮肤感染小鼠模型的建立及有效性验证[J].中国药科大学学报,2013,44(6):573-576.
[4]方泽鸿,杨志坚,曾宪鹏,等.大鼠皮肤伤口感染模型的建立[J].武汉大学学报(医学版),2018,39(3):412-416.
[5]李东明,蒋丽潇.皮肤细菌感染的病因、症状、诊断和治疗[J].皮肤性病诊疗学杂志,2011,18(3):218-219.
[6]万东芳,万永山,朱红军,等.皮肤软组织感染患者金黄色葡萄球菌感染状况研究[J].中华医院感染学杂志,2019,29(1):32-35.
[7]吴春雨.瑞香狼毒花化学成分的研究[D].内蒙古大学,2013.
[8]沈佳钰.瑞香狼毒药理活性研究进展[J].内蒙古中医药,2017,36(8):151-152.
[9]刘淑娜.瑞香狼毒的化学成分和生物活性的研究[D].北京中医药大学,2018.
[10]梁霞,陈知英.含积雪草的中药膏剂治疗皮肤感染效果观察[J].智慧健康,2019,5(11):165-166.
关注SCI论文创作发表,寻求SCI论文修改润色、SCI论文代发表等服务支撑,请锁定SCI论文网! 文章出自SCI论文网转载请注明出处:https://www.lunwensci.com/yixuelunwen/14528.html